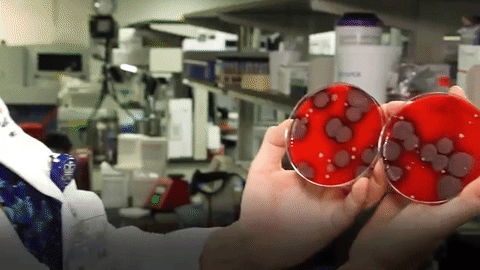
Testirali mobitele na bakterije i ono &scaron;to su na&scaron;li prilično je odvratno

Testirali mobitele na bakterije i ono što su našli prilično je odvratno
I to mi svakog dana vrtimo po rukama i stavljamo na lice?
Slobodno možemo reći da smo pravi ovisnici o mobitelima jer ih nosimo svuda sa sobom pa nekada čak i u kupaonicu, a sve zbog toga da ne bismo slučajno propustili nešto važno.
Ono o čemu ne razmišljamo na dnevnoj bazi jest to da oni vrve bakterijama, kao i drugi gadgeti. Iako bakterije ne možemo izbjeći jer koegzistiramo s njma, možemo izbjeći mnoge bolesti ako redovito čistimo stvari s kojima dolazimo u kontakt.
Osim bakterija koje se mogu naći na rukama, neki mobiteli bili su preplavljeni patogenim bakterijama koje potenciraju zarazu. Pronađene su čak i fekalne bakterije jer 75 % ispitanika koristi mobitel kada obavlja nuždu.
Što reći? Čistite svoje telefone antibakterijskim maramicama ili alkoholom te ih ne nosite na wc. Uzmite si vremena i obavite nuždu na miru, informacije neće pobjeći.
Više u videu.



![[KVIZ] Provjeri svoje znanje o baletu](http://cdn2.net.hr/media/2026/01/14/1443762/H-750bc17f-0409-4987-93b3-6aa58ba1f1bd-550.webp?1768401007)









![[KVIZ] Provjeri svoje znanje o baletu](http://cdn2.net.hr/media/2026/01/14/1443762/K-750bc17f-0409-4987-93b3-6aa58ba1f1bd-160.webp?1768401007)
